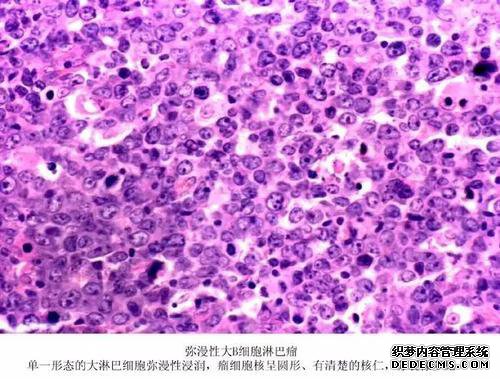

热门文章
医生为什么要留下意见?
发布时间:2019-10-06 23:38来源:365bet育在线网址点击率:
症状的原因:原因:疼痛通常是由有害刺激引起的,该刺激引起组织损伤。
外部因素:机械刺激(例如切刀和粘合)以及物理和化学因素(例如电流,高温,强酸和强碱)可能是有害刺激。
内部因素:当诸如癌症的疾病引起炎症或组织细胞损伤时,诸如钾离子,5-羟色胺,乙酰胆碱,缓激肽,组胺之类的生物活性物质可能会释放到细胞外液或痛觉过敏中
其他因素:感冒后疼痛,由于潮湿而过度疲劳,不适当的长期工作姿势。
病理:自由基神经末梢,在全身及相关组织中皮肤分化程度最低。作为伤害感受器,各种形式的有害能量诱导的刺激会沿着最薄的骨髓的较慢传输直径变成特定类型的神经冲动。鞘和最细的无髓传入神经纤维被传输。背根神经节到达脊髓或三叉神经核的背角,并通过对侧腹侧神经传递到较高的疼痛中心。引起情绪和痛苦反应的大脑和大脑皮层。
同时,与疼痛无关的信息(例如传入神经纤维传递的接触和压力)相对较快地到达中枢神经系统的相关大脑区域,并与细纤维传递的疼痛信息相互作用。的。
外部因素:机械刺激(例如切刀和粘合)以及物理和化学因素(例如电流,高温,强酸和强碱)可能是有害刺激。
内部因素:当诸如癌症的疾病引起炎症或组织细胞损伤时,诸如钾离子,5-羟色胺,乙酰胆碱,缓激肽,组胺之类的生物活性物质可能会释放到细胞外液或痛觉过敏中
其他因素:感冒后疼痛,由于潮湿而过度疲劳,不适当的长期工作姿势。
病理:自由基神经末梢,在全身及相关组织中皮肤分化程度最低。作为伤害感受器,各种形式的有害能量诱导的刺激会沿着最薄的骨髓的较慢传输直径变成特定类型的神经冲动。鞘和最细的无髓传入神经纤维被传输。背根神经节到达脊髓或三叉神经核的背角,并通过对侧腹侧神经传递到较高的疼痛中心。引起情绪和痛苦反应的大脑和大脑皮层。
同时,与疼痛无关的信息(例如传入神经纤维传递的接触和压力)相对较快地到达中枢神经系统的相关大脑区域,并与细纤维传递的疼痛信息相互作用。的。
- 上一篇:意思是源
- 下一篇:没有了